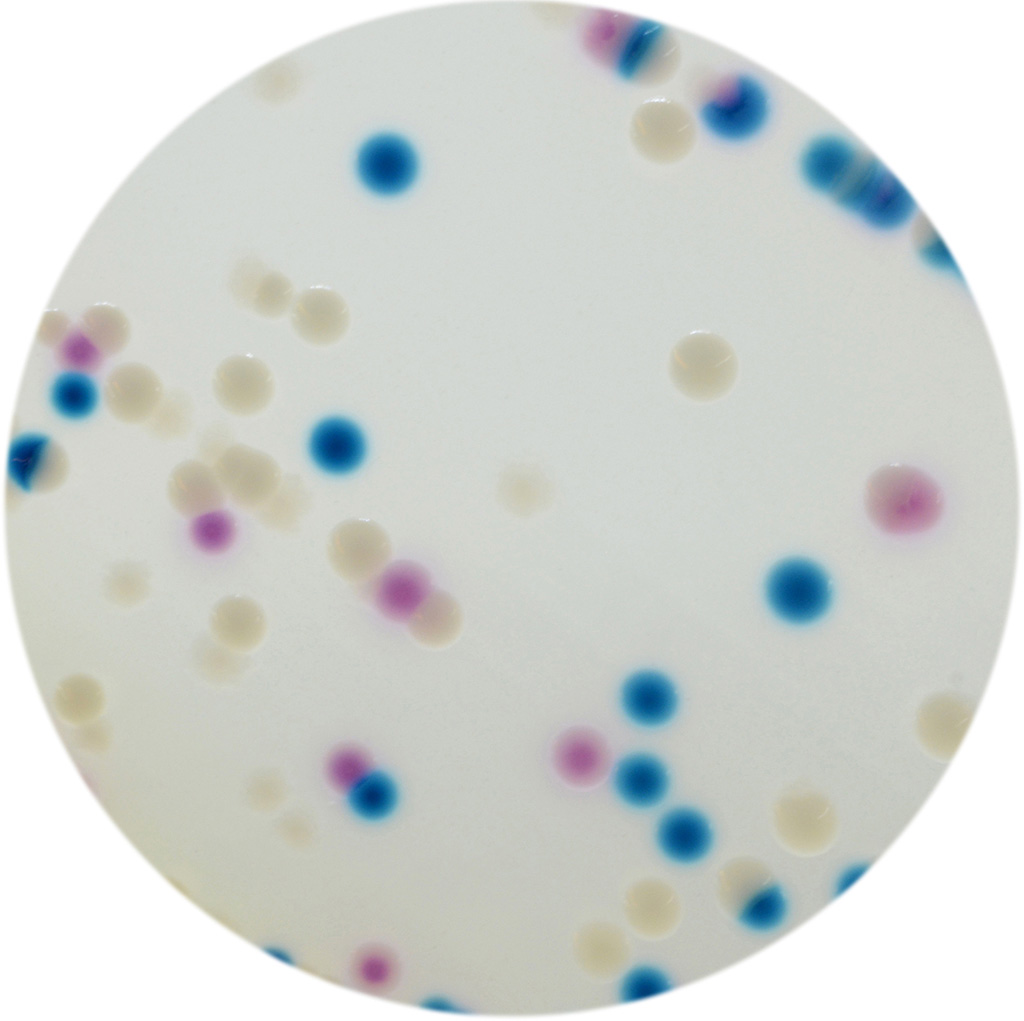

À propos du produit
CHROMagar COL-PASE est utilisé pour la détection des bactéries Gram négatives résistantes à la colistine.
CHROMAGAR COL-APSE
CHROMagar COL-PASE est utilisé pour la détection des bactéries Gram négatives résistantes à la colistine.